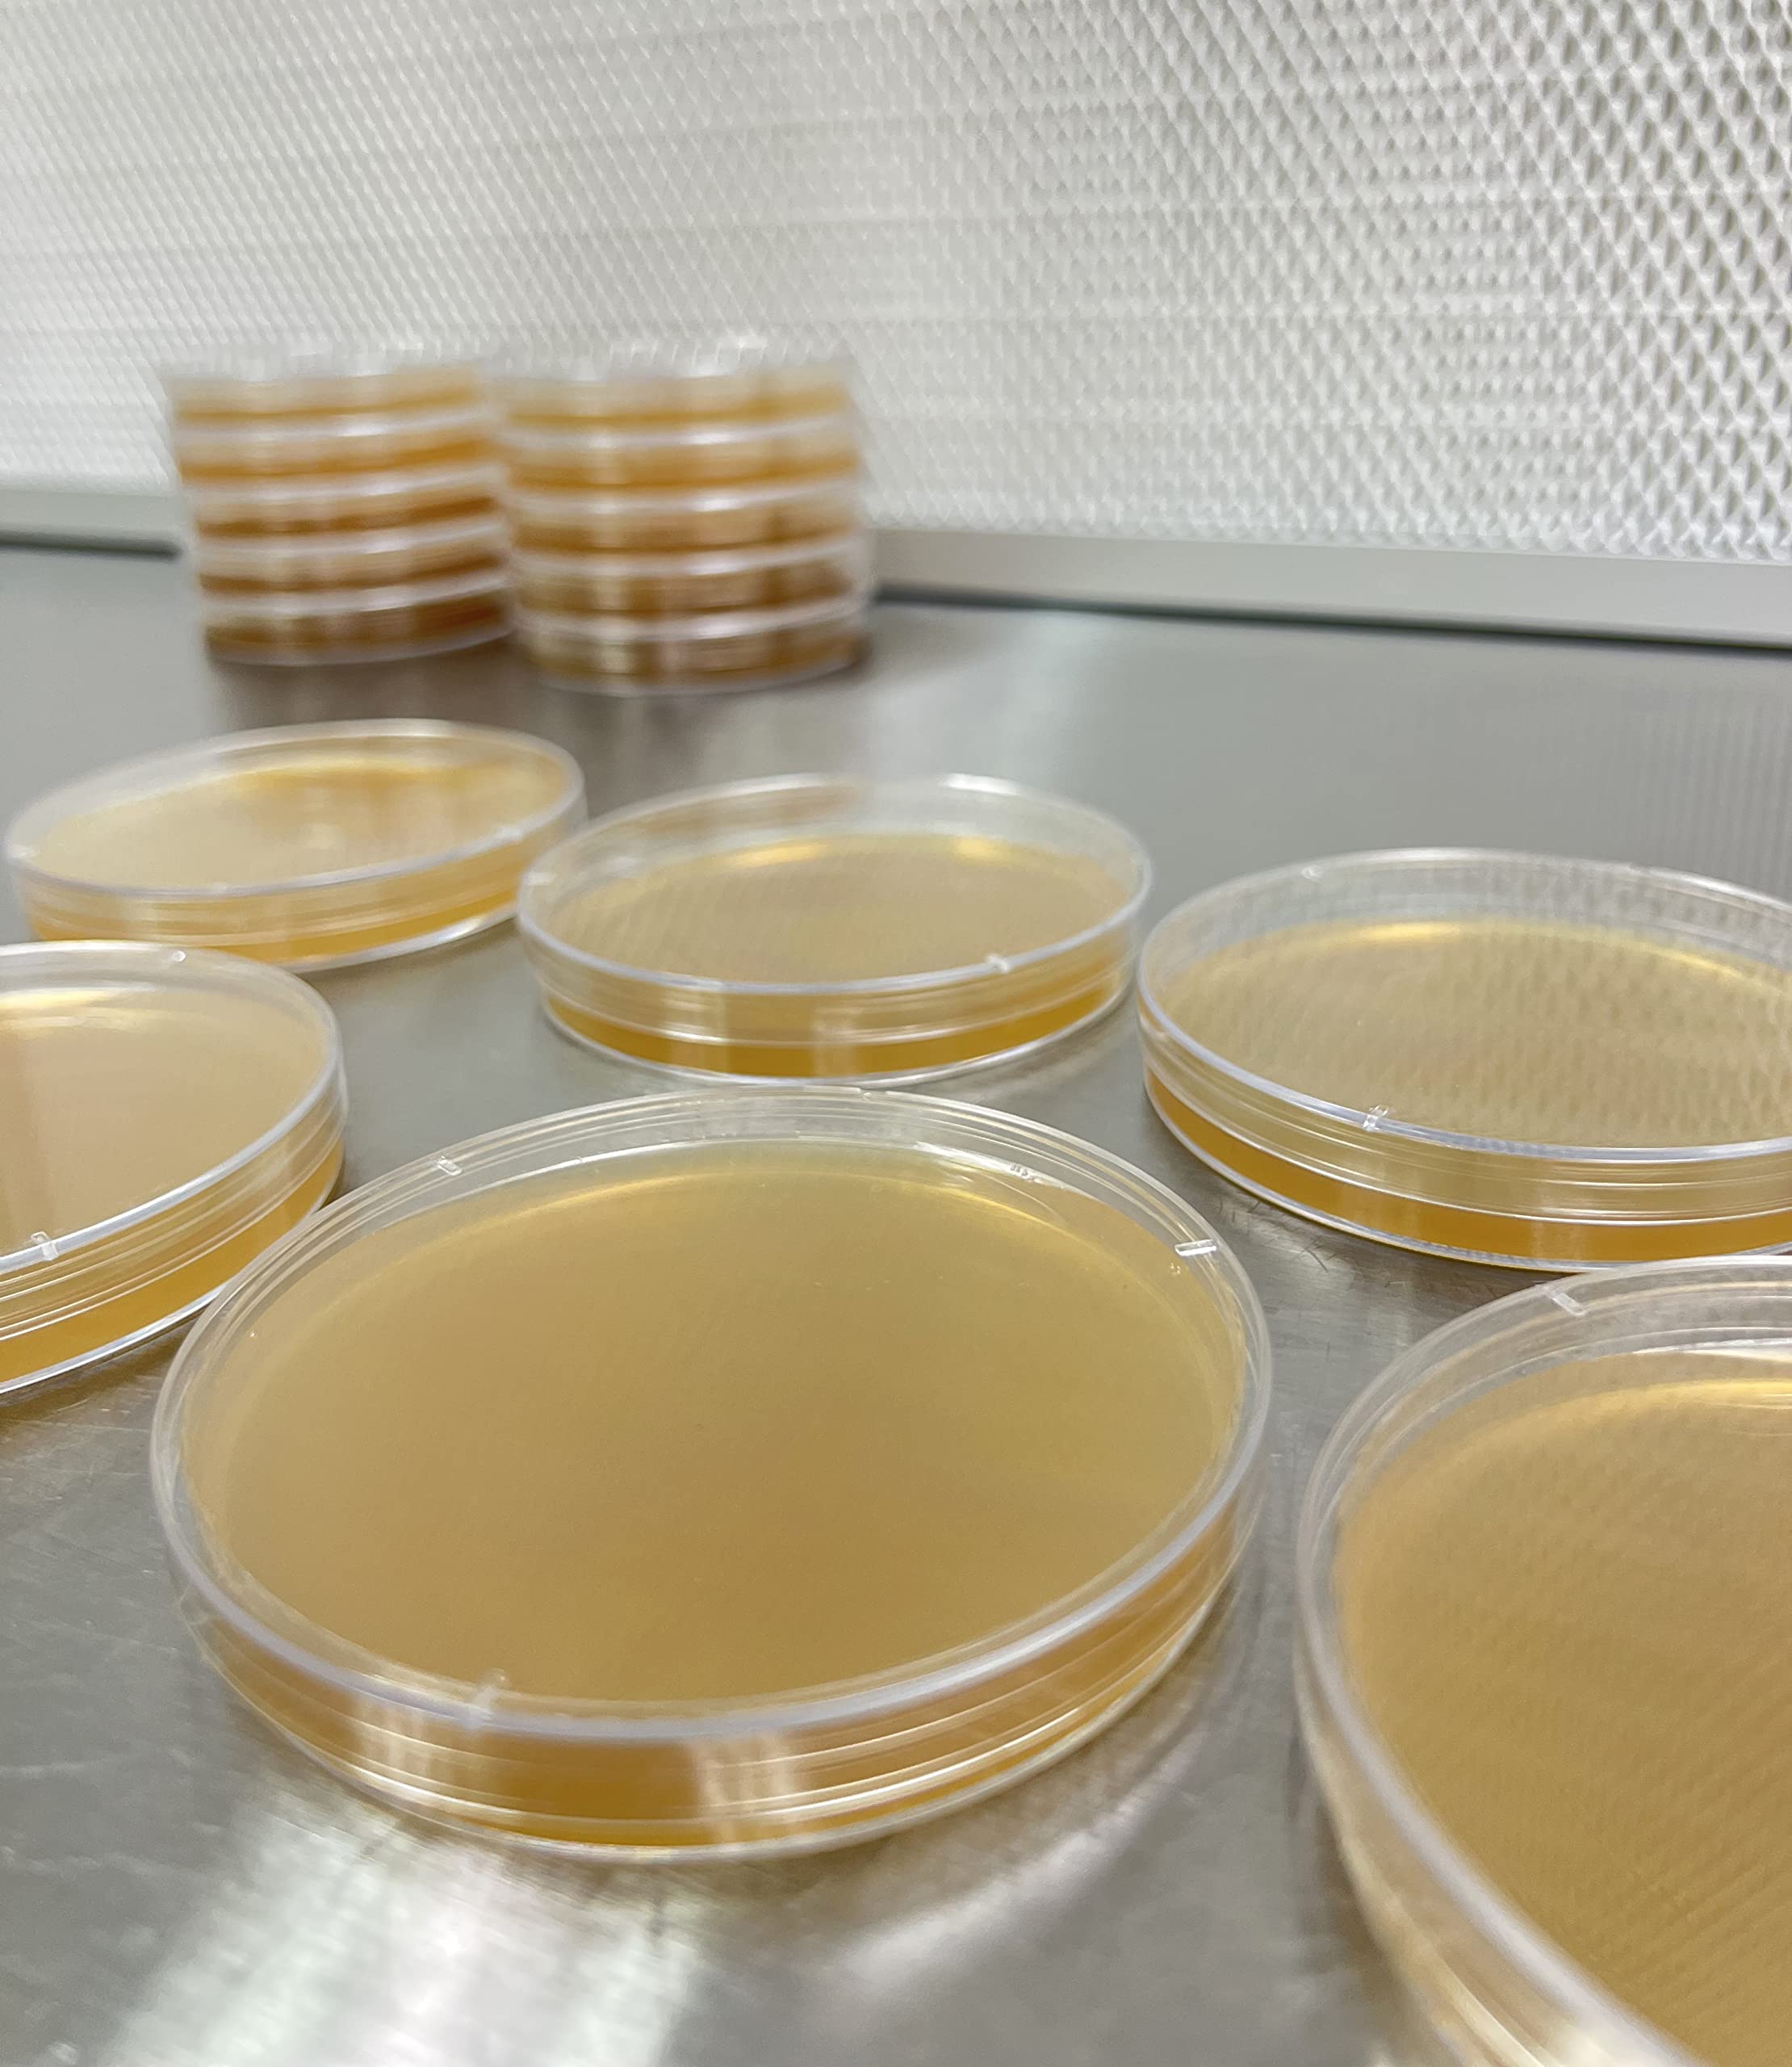
Thumbnail 3
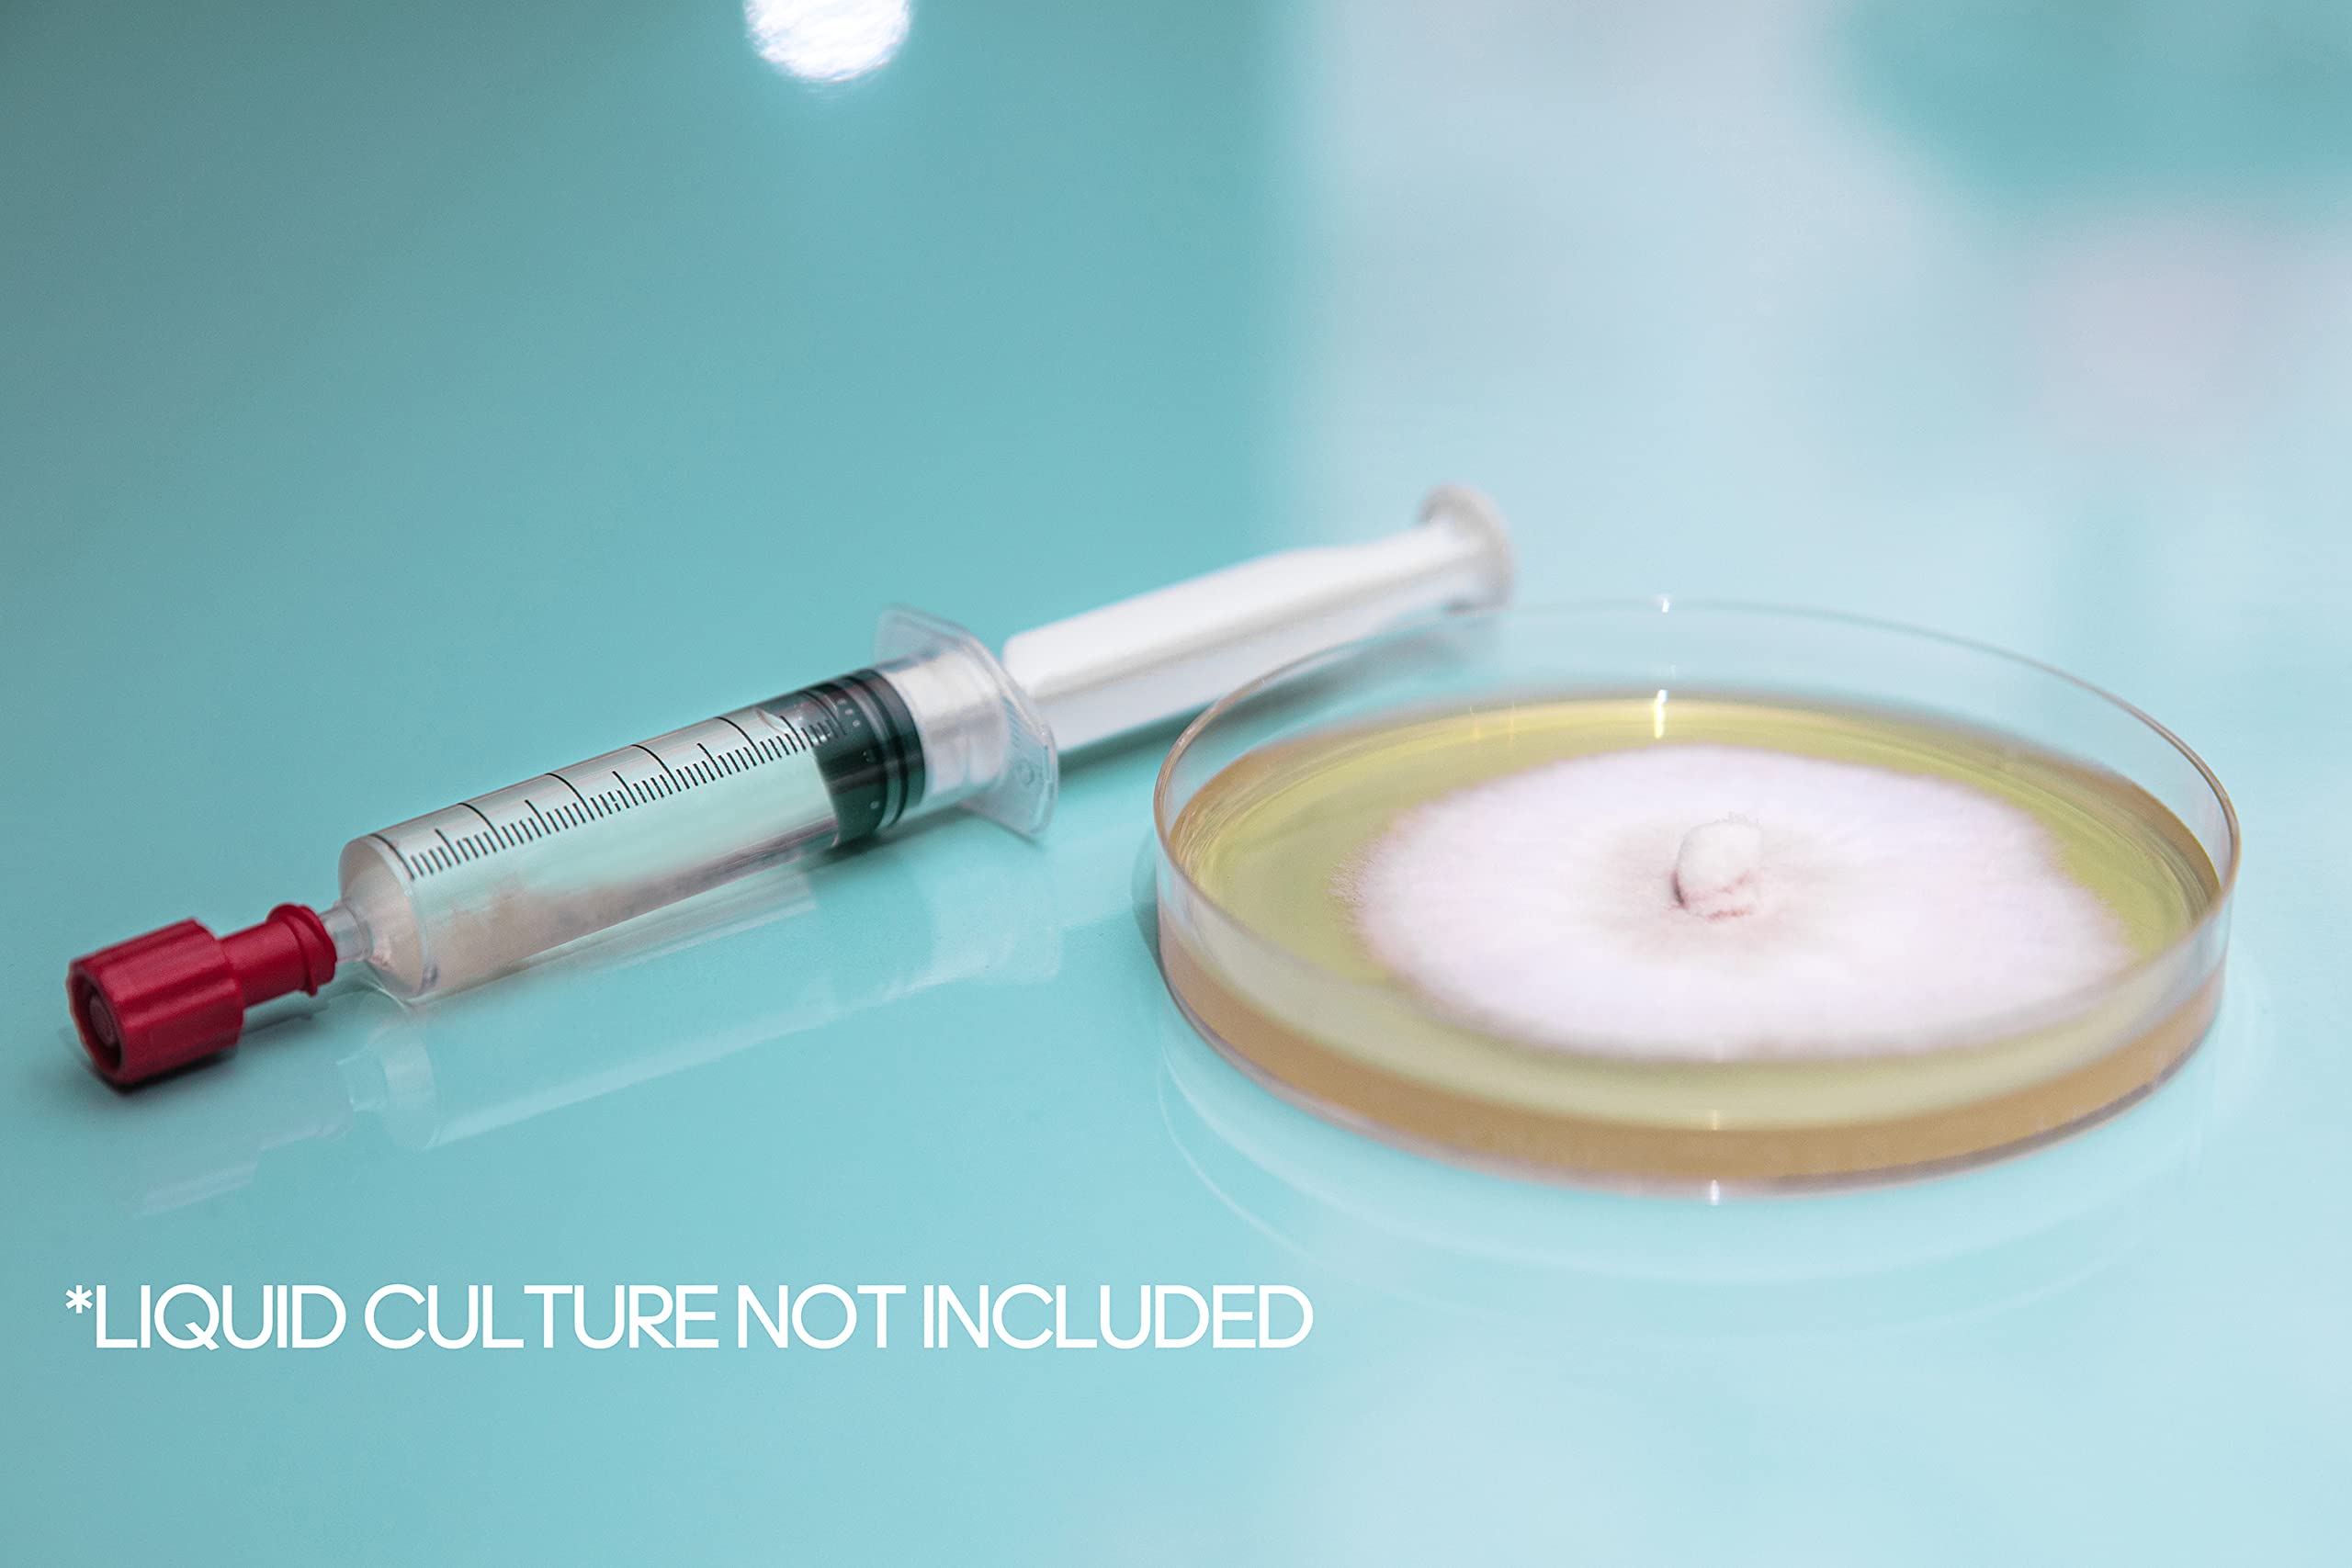
Thumbnail 5
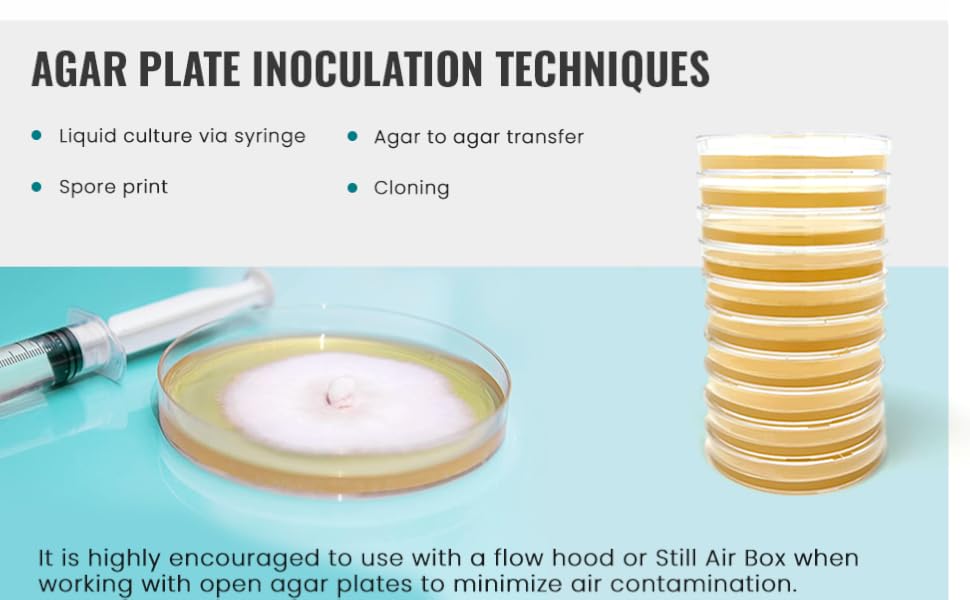
Large manufacture image 6

🌱 Grow Your Fungi Dreams with Ease!
Malt Yeast Extract Agar Plates (MYA) come in a pack of 10 sterile pre-poured Petri dishes, specially formulated for optimal mushroom mycelium growth. Each plate is pre-sterilized to ensure purity, making them perfect for both amateur and professional mushroom cultivation projects. With a commitment to customer satisfaction, Olympus Myco provides dedicated support for all your cultivation needs.

J**2
Great Plates / Amazing customer Service
I don’t write reviews but this company has top notch customer service. The plates are great and they are performing as they should. Although they were packaged very well one of the plates arrived cracked and I emailed them with a photo asking if there was anything they could do not thinking they would be able to do anything. They replied soon after and apologized and asked my order number and shipping information. Not even 5 minutes later they emailed me back thanking me for my purchase stating they are sending a couple replacement plates along with a tracking number and unbelievably they shipped it out that same day. I was shocked to be honest. Thanks!
W**.
Don’t buy. Worst plates on the market.
Bought once before. 3 plates after 2 days had contamination.Just got this delivery today and 4 plates have contamination on arrival. Opened the box it came in at my front door. Extremely poor quality. Non sterile techniques. Will never buy again. Thought the first time was a fluke but clearly I got lucky. 10/10 do not buy unless you want to waste money.
J**N
GREAT PRODUCT!!! WORKS AS EXPECTED
The quality of the Yeast Extract Agar Plates is exceptional. The agar medium is prepared with precision, ensuring a consistent and reliable substrate for mushroom growth.Arrived promptly with no visible signs of contamination. The pours are thick which is exactlyyy what I was looking for.
C**O
Works well
No contamination and working well.
R**.
Sterile?…No.
Second time purchasing these, first order was fine, second order not so much. 8 of the ten plates are seriously contaminated with trich bloom.I’m amending this review after the seller reached out and immediately replaced the contaminated plates with two sets of new plates in clean and sterile condition. I appreciate them taking responsibility and making things right.
S**O
great products
The agar plates arrived without any signs of contamination. They are producing some very healthy mushrooms cultures. I also like how thick the pours are.
B**C
Contaminated upon deliver and after a few days
I purchased 4 sets of these for a total of 40 and 1 set of 10 was contaminated right out of the box. All had condensation so I stored them upside down. Another set of 10 showed contamination a few days later. I never removed them from the plastic ziplock type bag. Why aren’t these individually sealed? I’m not impressed. Will return the 2 sets of 10 that are contaminated and look to purchase elsewhere. I would buy from someone else if I were you. Preferably from a manufacturer who can seal the plates individually then seal them in sets of 10. …Or just pour your own agar plates as I’m thinking of doing.
D**Y
Amazing Mycelium Growth
I grow mushrooms and these plates save me so much time. The pours were nice and thick. I have had issues with other brands before where the pours were very shallow. My mycelium cultures are growing like crazy. Highly recommend these agar plates!
Trustpilot
5 days ago
3 days ago
1 month ago
2 months ago